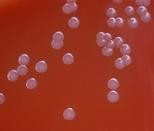

Материал: Литусов_Пиогенные кокки
Путь передачи менингококковой инфекции (один правильный ответ):
водный
пищевой
воздушно-капельный
трансплацентарный
инъекционный
Входные ворота менингококковой инфекции (один правильный ответ):
слизистая мочеполового тракта
слизистая оболочка носоглотки
кожные покровы
кишечник
раневая поверхность
К генерализованным формам менингококковой инфекции относятся (несколько правильных ответов):
бактерионосительство
менингококцемия
менингит
назофарингит
пневмония
К локализованным формам менингококковой инфекции относятся (несколько правильных ответов):
бактерионосительство
менингококцемия
менингит
назофарингит
пневмония
Материал для бактериоскопической диагностики менингококковой инфекции (несколько правильных ответов):
слизь из носоглотки
кровь
ликвор
испражнения
моча
При микробиологической диагностике менингококковой инфекции используют методы (несколько правильных ответов):
микроскопический
культуральный
серологический
аллергический
биологический
Основной метод микробиологической диагностики менингококкового назофарингита (один правильный ответ):
микроскопический
культуральный
серологический
аллергический
биологический
Для диагностики менингококковой инфекции используются методы (несколько правильных ответов):
культуральный
биологический
аллергический
латекс-агглютинации
метод микрокультур (метод Прайса)
Для выделения менингококков из ликвора используют (один правильный ответ):
среду Плоскирева
сывороточный агар
среду Эндо
среду Левина
висмут-сульфитный агар
При микроскопии мазков, приготовленных из ликвора больного менингитом, обнаруживаются (один правильный ответ):
грамотрицательные диплококки
грамположительные диплококки
грамотрицательные палочки в цепочке
грамположительные палочки
извитые бактерии
Препараты специфической профилактики менингококковой инфекции (один правильный ответ):
вакцины
антибиотики
пребиотики
пробиотики
диагностикумы
После генерализованных форм менингококковой инфекции формируется иммунитет (несколько правильных ответов):
длительный напряженный преимущественно гуморальный
длительный напряженный преимущественно клеточный
нестерильный
антибактериальный
антитоксический
Правильные ответы: 1.3; 2.2; 3.2; 4.1; 5.3, 5.4; 6.1, 6.4; 7.3, 7.5; 8.2, 8.4, 8.5; 9.3, 9.4;
10.1, 10.3; 11.2, 11.3, 11.4; 12.2; 13.3; 14.2; 15.2, 15.3; 16.1, 16.4; 17.1, 17.2, 17.3; 18.1,
18.2, 18.3; 19.2; 20.1, 20.4; 21.2; 22.1; 23.1; 24.1, 24.4.
Гонококки
Гонококковая инфекция (гонорея) - это инфекционное заболевание человека, вызываемое Neisseria gonorrhoeae, которое передается половым путем и характеризуется гнойным воспалением слизистой оболочки мочеполовых путей (гонорея), конъюнктивы глаз (бленнорея) или других органов.
N. gonorrhoeae относится к типу Proteobacteria, классу Betaproteobacteria, порядку Neisseriales, семейству Neisseriaceae, роду Neisseria.
Возбудитель гонореи был открыт А. Нейссером в 1879 г. Этиологическую роль N. gonorrhoeae в развитии гонореи доказал в 1885 г. немецкий акушер- гинеколог Э. Бумм (рисунок 2.27).

Рисунок 2.27 - Эрнст Бумм (Ernst Bumm, 1858 – 1925 гг.). Заимствовано из Интернет-ресурсов.
Морфологические и тинкториальные свойства. Гонококки представляют собой неподвижные диплококки размером 1,25÷1,0x0,7÷0,8 мкм. Они хорошо окрашиваются анилиновыми красителями (метиленовым синим, бриллиантовым зеленым и др.). По Граму окрашиваются в розовый цвет, то есть являются грамотрицательными (рисунок 2.28).


а б
Рисунок 2.28 - Гонококки, форма клеток, компьютерная визуализация (а) и окраска по Граму (б). Заимствовано из Интернет-ресурсов.
Под действием пенициллина гонококки способны образовывать L-формы: округлые образования, превышающие в несколько раз в диаметре исходные клетки (рисунок 2.29).

Рисунок 2.29 - L-формы гонококков (указаны стрелкой). Заимствовано из Интернет- ресурсов.
Гонококки образуют нежную капсулу (рисунок 2.30) и пили, спор не образуют.

Рисунок 2.30 - Капсула у гонококков. Заимствовано из Интернет-ресурсов.
Культуральные свойства. Гонококки являются аэробными микроорганизмами. Оптимальная температура культивирования 37ОС, оптимальное значение рН - 7,2-7,4. Гонококки требовательны к питательным средам. Для их выращивания используют среды, содержащие кровь, сыворотку крови или асцитическую жидкость. На плотных питательных средах через 24 часа инкубирования при оптимальной температуре гонококки образуют слегка мутные или прозрачные бесцветные колонии круглой формы с ровными краями диаметром 1-3 мм. На средах с кровью гемолиза не вызывают (рисунок 2.31).
Рисунок 2.31 - Колонии гонококка на кровяном агаре. Заимствовано из Интернет- ресурсов.
В жидких питательных средах гонококки образуют поверхностную пленку, через несколько дней оседающую на дно пробирки.
Биохимическая активность гонококков крайне низкая. Они разлагают только глюкозу с образованием кислоты без газа (рисунок 2.32), продуцируют каталазу и цитохромоксидазу.
Глюкоза Мальтоза Лактоза Сахароза
Рисунок 2.32 – Ферментация углеводов гонококками.
Протеолитическая активность отсутствует, аммиака, сероводорода и индола не образуют.
Резистентность. Гонококки неустойчивы во внешней среде. При температуре 56ОС они погибают в течение 5 минут, при 100ОС - мгновенно. Гонококки чувствительны к действию многих антисептиков и дезинфектантов. Они обладают высокой чувствительностью ко многим антибиотикам, в том числе к пенициллинам. Однако в последнее время получили распространение штаммы, устойчивые к антибиотикам. В частности, штаммы, устойчивые к пенициллину, продуцируют β-лактамазы, синтез которых обусловлен наличием R-плазмид.
Антигенная структура. Гонококки содержат следующие антигены:
соматический антиген;
капсульный антиген;
липоолигосахарид (ЛОС);
антигены пилей;
белки наружной мембраны.
Среди антигенов гонококков основная роль принадлежит антигенам пилей и белкам наружной мембраны. Пили состоят из белковых субъединиц, остатков сахаров и фосфорной кислоты. Последовательность соединения белковых субъединиц пилей может меняться, в результате чего изменяются антигенные свойства клеток. Наружная мембрана содержит протеины разных классов. Эти протеины проявляют сильные иммуногенные свойства. По составу протеинов наружной мембраны выделяют несколько серотипов гонококков. Антитела к протеинам клеточной стенки гонококков в присутствии комплемента проявляют бактерицидные свойства.
Факторы патогенности гонококков (рисунок 2.33):
капсула;
пили (фимбрии);
липоолигосахарид (ЛОС);
поверхностные белки наружной мембраны;
трансфериновые рецепторы TbrA и TbrB;
IgA-протеаза;
гиалуронидаза;
рибосомальный белок.
Капсула
L12-протеин
Rmp Ора
IgA-Протеаза
Пили
Гиалуронидаза
ЛОС
TbrA, TbrB
Por
 Рисунок
2.33 – Основные факторы патогенности
гонококков.
Рисунок
2.33 – Основные факторы патогенности
гонококков.
Все свежевыделенные культуры имеют капсулу, которая состоит из полифосфатов. Капсула препятствует фагоцитозу и маскирует антигены клеточной стенки гонококков.
Пили (рисунок 2.34) состоят из белка пилина и обеспечивают адгезию гонококка к эпителиальным клеткам. Изменение структуры пилина приводит к изменению антигенного состава фимбрий. Вариабельность строения пилей способствует выживаемости гонококков на эпителиальных клетках при смене хозяина и воздействии антител. Клетки, не имеющие пилей, заболевания не вызывают. Утрата гонококками пилей называется сменой фаз роста. Смена фаз роста позволяет гонококкам отрываться от эпителиальных клеток и разноситься по организму.

Рисунок 2.34 - Капсула и пили гонококков, компьютерная визуализация.
Заимствовано из Интернет-ресурсов.
Липоолигосахарид (ЛОС) гонококков отличается от липополисахаридов других грамотрицательных бактерий тем, что имеет ядро и не имеет боковой цепи
(О-антигена). Липоолигосахарид способен изменять антигенный состав, что позволяет гонококкам уклоняться от воздействия иммунной системы. Липоолигосахарид обусловливает продукцию медиаторов воспаления – цитокинов. Схожесть гонококкового липоолигосахарида с гликосфинголипидом мембран клеток организма человека позволяет микробу избегать иммунного распознавания.
Поверхностный белок наружной мембраны I класса (белок РI, Por- белок) является порином. Он встраивается в наружную мембрану эпителиальных клеток и формирует в ней каналы, что способствует проникновению возбудителя в клетки. Внутри эпителиальных клеток этот белок препятствует слиянию лизосомы с фагосомой, в результате чего гонококки длительное время остаются жизнеспособными внутри клеток.
Поверхностный белок II класса (Ора-протеин, протеин мутности, инвазин) способствует плотному прилеганию гонококков к эпителиальным клеткам и их инвазии внутрь клеток. Наличие этого белка обусловливает мутность колоний гонококков (например, при исследовании материала из уретры мужчин). При отсутствии этого белка колонии гонококков становятся прозрачными (в частности, при исследовании крови, синовиальной жидкости).
Поверхностный белок III класса (Rmp-белок) осуществляет защиту гонококка от антител класса IgM.
Трансфериновые рецепторы TbrA и TbrB взаимодействуют с трансферином человека и извлекают из него железо (“железо-добывающие” белки).
IgA-протеаза расщепляет секреторный иммуноглобулин А, в результате чего инактивируются антитела слизистых оболочек, препятствующие адгезии бактерий к рецепторам эпителиальных клеток.
Гиалуронидаза способствует распространению гонококков в межклеточном пространстве.
Рибосомальный белок (L12-протеин) отвечает за возникновение восходящей гонореи у женщин.
Эпидемиология. Гонорея относится к наиболее распространенным инфек- ционным заболеваниям, передаваемым половым путем. В мире ежегодно более 60 млн. человек заболевают этой инфекцией. В частности, в Российской Федерации в 2005 г. было зарегистрировано 99911 случаев гонококковой инфекции, в 2008 г. – 80100 случаев.
Источником инфекции при гонорее является больной человек, особенно с хронической бессимптомно протекающей формой болезни. Механизм передачи возбудителя - контактный, путь передачи - половой. Восприимчивость к гонококковой инфекции очень высокая.
Патогенез. Входными воротами для возбудителя гонококковой инфекции служит цилиндрический эпителий уретры, шейки матки, конъюнктивы, глотки и дистального отдела прямой кишки. На слизистой оболочке гонококки с помощью пилей закрепляются на поверхности эпителиальных клеток. В месте входных ворот посредством IgA-протеазы и поверхностных белков возбудитель подавляет защитные факторы организма и размножается, колонизируя эпителий (рисунок 2.35).

Рисунок 2.35 - Колонизация гонококками слизистой оболочки (компьютерная визуализация). Заимствовано из Интернет-ресурсов.
Под действием ЛОС происходит синтез цитокинов, вызывающих развитие воспалительной реакции. В результате этого наступает гибель и слущивание эпителиальных клеток, нарушается процесс самоочищения слизистых оболочек. Затем Por-белок гонококка встраивается в мембрану эпителиальных клеток, и с помощью Ора-белка наружной мембраны возбудитель проникает путем эндоцитоза (“непрофессионального” фагоцитоза) внутрь эпителиальной клетки с образованием фагосомы. Внутри клетки фагосомы сливаются, формируя вакуоли, в которых гонококки размножаются. В дальнейшем вакуоли сливаются с базальной мембраной эпителиальных клеток, а гонококки проникают в субэпителиальную ткань или в кровоток. В субэпителиальной ткани часть гонококков, сохранивших пили, прикрепляется к клеткам и перемещается на соседние участки. Другая часть гонококков поглощается фагоцитами и инфицирует ткани. Гематогенное диссеминирование инфекции отмечают у 1% заболевших. Таким образом, в развитии гонококковой инфекции возможны локальные или системные проявления (рисунок 2.36).
Локальная инфекция
Гранулоцит прилипание внедрение
внутриклеточное существование
лимфоцит
эндотелиальная клетка
моноцит
Системная инфекция
Рисунок 2.36 - Патогенез гонококковой инфекции. Заимствовано из Интернет-ресурсов.
Генерализованная гонококковая инфекция возникает редко. При генерализованной форме поражаются суставы, кожа, сердце, мозговые оболочки.
Клиника. Инкубационный период составляет от 12 часов до 7 суток (в среднем 3 суток). У женщин и у 10% мужчин гонококковая инфекция протекает бессимптомно. Гонококковая инфекция проявляется в виде гнойного воспаления слизистой мочеполовых путей (гонорея), конъюнктивы глаз (бленнорея) и других органов. Гонококковый уретрит (воспаление слизистой мочеиспускательного канала) – самое частое проявление гонореи у мужчин. При этом отмечается острое начало заболевания с обильными гнойными выделениями из уретры (рисунок 2.37), резью и болью при мочеиспускании.

Рисунок 2.37 - Гонококковый уретрит. Заимствовано из Интернет-ресурсов.
У женщин гонорея проявляется гонококковым цервицитом - поражением шейки матки и эндоцервикального канала (рисунок 2.38).

Рисунок 2.38 - Гонококковый цервицит. Заимствовано из Интернет-ресурсов.
Практически всегда гонококковый цервицит протекает бессимптомно. В редких случаях отмечаются жалобы на появление скудных выделений из влагалища и боль в нижней части живота. Бессимптомное течение приводит к раннему развитию осложнений гонококковой инфекции.
При гонококковом проктите (рисунок 2.39) наиболее часто отмечаются зуд, жжение в заднем проходе, незначительные гнойные выделения, болезненные позывы к дефекации.

Рисунок 2.39 - Гонококковый проктит. Заимствовано из Интернет-ресурсов.
Гонококковый фарингит (рисунок 2.40) возникает вследствие орогенитальных половых контактов. Клинически гонококковый фарингит зачастую протекает бессимптомно и обнаруживается лишь при бактериологическом исследовании. Изредка пациентов могут беспокоить сухость и першение в глотке, боль, усиливающаяся при глотании.

Рисунок 2.40 - Гонококковый фарингит. Заимствовано из Интернет-ресурсов.
Гонококковый конъюнктивит (рисунок 2.41) сопровождается резкой болезненностью, слезотечением, припухлостью век, светобоязнью, появлением обильного гнойного отделяемого. Чаще поражается один глаз.


Рисунок 2.41 - Гонококковый конъюнктивит. Заимствовано из Интернет-ресурсов.
Гонококковая инфекция имеет тенденцию к переходу в хроническую бессимптомную форму. При отсутствии лечения гонорея часто является одной из основных причин бесплодия как у мужчин, так и у женщин.